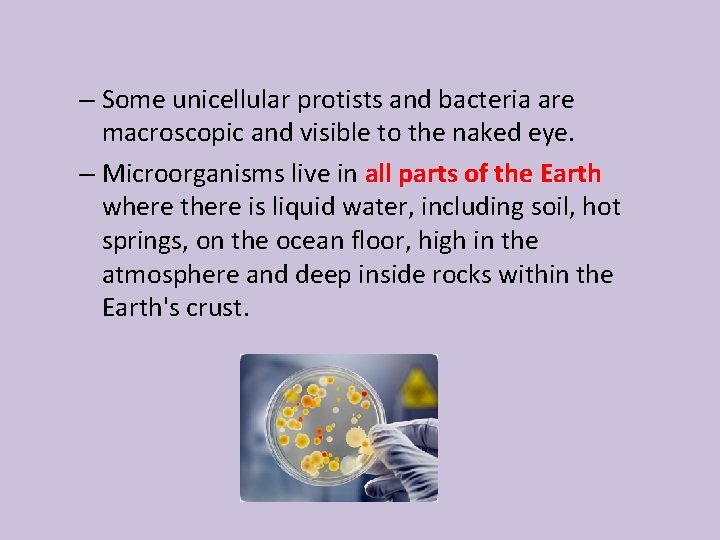
– Some unicellular protists and bacteria are macroscopic and visible to the naked eye.

Vocabulary Words Microorganisms Unicellular Multicellular Prokaryote Eukaryote Autotrophs

Vocabulary Words • • • Microorganisms Unicellular Multicellular Prokaryote Eukaryote • • • Autotrophs Heterotrophs Flagellum Cilium Pseudopod

Microorganisms Single Celled Organisms http: //www. youtube. com/watch? v=t q. OVYpk. Z 0 qs http: //www. youtube. com/watch? v=Rpj 0 em. EG Sh. Q

• Microorganism – Comes from the Greek words, mikrós, meaning "small" and organismós, meaning "organism. “ – Microorganisms are also known as microbes. – The study of microorganisms is called microbiology. – Anton van Leeuwenhoek's discovered microorganisms in 1675 using a microscope of his own design. – A microscopic organism comprises either a single cell, cell clusters. • Unicellular organism is an organism made of only one cell.

– Cells are the basic unit of structure in most living organisms. – Cells have different shapes & characteristics based on their function. – Most cells consist of a… • Cell membrane or the outside boundary that separates the cell from the environment. • Cytoplasm or the thick gel-like substance located within the cell membrane & houses all organelles of the cell. • Nucleus or the location of most of the genes & organelles that directs the majority of the cell’s activities.

– There are 2 main categories of cells 1. Prokaryotic cells • Cells that do not contain a nucleus • Ex. ) Bacteria & Achaea 2. Eukaryotic cells • Cells that do contain a nucleus • Ex. ) Plant cells, animal cells, protists, & fungi

– Microorganisms are very diverse; they include bacteria, fungi, and protists. – They also include microscopic plants (green algae) and animals such as plankton. – Most microorganisms are unicellular (singlecelled) however some multicellular organisms are microscopic.
– Some unicellular protists and bacteria are macroscopic and visible to the naked eye. – Microorganisms live in all parts of the Earth where there is liquid water, including soil, hot springs, on the ocean floor, high in the atmosphere and deep inside rocks within the Earth's crust.

– Microorganisms can also be autotrophic or heterotrophic. • An autotroph is an organism that can make their own food typically through photosynthetic processes. • A heterotroph is an organism that cannot make their own food. – Microorganisms are critical to nutrient recycling in ecosystems as they act as decomposers.

• Methods of movement in some microorganisms – Flagellum (flagella, pl. ) • A long cellular appendage specialized for locomotion or movement • “tail-like ” structure attached to the outer membrane of some cells & cellular organisms. • Moves in a snake-like, side-winding motion. – Ex. Sperm cells – Cilium (cilia, pl. ) • A short cellular appendage specialized for locomotion or movement; • “hair-like” structures that outer membrane of some cells & cellular organisms. • Moves in a back-and-forth motion moving at about 40 -60 strokes per second. – Ex. Paramecium

– Pseudopod • A temporary foot like extension of a one-celled organism, such as an amoeba, used for moving about and for surrounding and taking in food • Ex: amoeba

• Examples of common microorganisms 1. Bacteria • One-celled, non-nucleus containing microorganism that comes in various shapes from spheres, to rods, to spirals. – Toxin: A poison produced by bacterial pathogens that damage cells. • Diseases caused by bacteria – – – – Tetanus Typhoid fever Diphtheria, Syphilis, Cholera, Leprosy Tuberculosis (TB)

2. Virus • a small acellular organism that can replicate only inside the living cells of organisms. • Most viruses are too small to be seen directly with a light microscope. • Viruses infect all types of organisms, from animals and plants to bacteria. • 1 st discovered in 1898, there are millions of different types. • Diseases caused by viruses include – Influenza (Flu) – Common cold – Chicken pox – SARS – HIV/AIDS

3. Fungi • Many fungi are parasites on plants and animals, including humans. • Some fungi can cause serious diseases in humans several of which may be fatal if untreated. • Diseases caused by fungi include… – – Ringworm Athlete’s foot Toxic black mold Mold/Fungus specific allergies 4. Protists • Unicellular or multi-cellular organism without specialized tissues. • Diseases caused by protists include… – Malaria – African sleeping sickness – Amebic dysentery
- Slides: 13